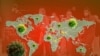

Evropske zemlje, uprkos upozorenjima Svetske zdravstvene organizacije, počinju da ukidaju restriktivne mere koje su uvedene kako bi se kontrolisala pandemija korona virusa i suzbilo njegovo širenje.
Broj obolelih u svetu se približava brojci od dva miliona, a umrlo je više od 120.000 ljudi. Skoro 90 odsto infekcija dolazi iz Evrope i SAD, poručuju iz Svetske zdravstvene organizacije. Izlečenih je skoro pola miliona.
Zašto podaci ne pokazuju cijelu sliku?
Dnevna kompilacija slučajeva zaraženih korona virusom koje objavljuje Univerzitet Johns Hopkins je najkompletnija na svijetu, ali se oslanja na informacije koje dostavljaju vlade pojedinih država.
U mnogim zemljama postoje restrikcije o objavljivanju takvih informacija ili drugi razlozi zašto se ne želi prikazati puna slika.
Metodologija, direktnost, transparentnost i kvalitet ovih podataka može dramatično varirati od zemlje do zemlje.
Austrija otvara neke prodavnice
Austrija otvara hiljade prodavnice i popušta restrikcije kretanja koje su uvedene kako bi se sprečilo širenje korona virusa u toj zemlji. Garden centri, prodavnice alata i male radnje biće otvorene kao deo plana o postepenom pokretanju ekonomije.
Pravila strogog fizičkog distanciranja i dalje ostaju na snazi, a ljudima se preporučuje da ostanu kod kuće koliko god je to moguće. Austrija je uvela i obavezu nošenja maski u supermarketima i apotekama.
Poljska ublažava mere od 19. aprila
Primer Austrije pratiće i Poljska, koja je najavila da će od 19. aprila početi da ublažava restrikcije i da postepeno pokreće privredu.
"Cena potpunog zatvaranje zemlje iznosi 2,2 milijarde evra na dan, dva. Ako ne odmrznemo privredu ljudi će umirati od drugih bolesti, a ne od Covid-19", kazao je poljski ministar zdravlja Lukaš Šumovski.
Dodao je i da nema preciznih podataka o tome da će epidemija usporiti tokom leta.
"Prema mojoj oceni epidemija će trajati najmanje godinu dana. Moramo da se pripremimo na dugi rat", rekao je ministar i poručio da Poljaci mogu da zaborave na letovanja ove sezone.
Poljska je jedna od retkih zemalja koja, uprkos epidemiji, ne odustaje od održavanja predsedničkih izbora u toj zemlji koji su zakazani za 10. maj. Vladajuća partija Pravo i pravda očekuje ubedljivu pobedu svog kandidata i aktuelnog predsednika Andžeja Dude, a prema poslednjim informacijama, oni planiraju da se izbori održe poštom.
"Bez sumnje, izbori poštom bezbedniji su nego tradicionalni izbori", kazao je Šumovski.
Prema podacima uod utorka (14. aprila) ujutro, u Poljskoj je virusom korona zaraženo skoro sedam hiljada ljudi, 245 je preminulo dok je ozdravilo 618. Do sada je testirano skoro 150.000 ljudi.
U Nemačkoj manje zaraženih zbog Uskrsa
Broj zaraženih u Nemačkoj je prethodnih dana u padu zbog smanjenog testiranja tokom uskršnjih praznika, saopšteno je iz Instituta Robert Koh.
"Nema naznaka da će brojke dodatno opadati. Moramo biti strpljivi i ostati disciplinovani", rekao je direktor Robert Koh Instituta.
Nemačka je, inače, jedna od retkih zemalja koja sprovodi masovna testiranja, jer time želi da identifikuje što veći broj zaraženih, kako bi epidemiju stavila pod kontrolu. Do sada je u Nemačkoj potvrđeno više od 125.000 zaraženih, od čega je umrlo oko 3.000 ljudi. Samo u prethodnom danu je zabeleženo više od 2.000 novih infekcija.
Kancelarka Angela Merekel i drugi zvaničnici više puta su ponavljali da je uskršnji vikend ključan za kontrolisanje epidemije i apelovali na Nemce da ostanu disciplinovani i kod svojih kuća, kako ne bi imali veliki broj kontakata tokom praznika.
Francuska u karantinu do 11. maja
Nacionalni karantin u Francuskoj ostaje na snazi do 11. maja, saopštio je sinoć u obraćanju naciji francuski predsednik Emanuel Makron.
"Tada ćemo ući u novu fazu borbe protiv virusa i postepeno ćemo krenuti da otvaramo škole i zabavišta", naveo je Makron.
Francuska vlada predviđa pad BDP-a od osam odsto za 2020. godine zbog pandemije korona virusa koja je paralisala ekonomiju u toj zemlji.
U Francuskoj je do sada potvrđeno skoro 100.000 obolelih od korona virusa, dok je umrlo skoro 15.000 ljudi. To je, zajedno sa SAD, Italijom, Španijom i Velikom Britanijom, svrstava među pet najpogođenijih država korona virusom u svetu.
Putin upozorio na najgori scenario
Rusija suočava sa povećanim brojem teško obolelih od korona virusa i mora da se pripremi za "najgori scenario", poručio je ruski predsednik Vladimir Putin.
Putin je naredio zvaničnicima da angažuju dodatno osoblje sa univerziteta i medicinskih škola.
Broj zaraženih u Rusiji je prešao 20.000, a juče je zabeležen najveći porast infekcija u jednom dana, skoro 3.000. Oko dve trećine svih slučajeva je u Moskvi i okolini. U Rusiji je do sada od korona virusa umrlo oko 170 ljudi.
Turska usvojila zakon o oslobađanju zatvorenika
Turski parlament usvojio je zakon na osnovu kog će biti oslobođeno oko 90.000 zatvorenika, a sve u cilju smanjivanja prenatrpanosti u zatvorima zbog pandemije korona virusa.
Zatvorenici sa presudama vezanim za drogu, seksualno zlostavljanje, ubistvo, nasilje u kući i terorizam nisu obuhvaćeni ovom merom koja treba da smanji sadašnju zatvorsku populaciju od preko 280.000 zatvorenika.
Desetine novinara, opozicionih aktivista, političara i drugih ostaju u zatvoru zato što su mnogi od njih pritvoreni po optužbama vezanim za terorizam.
Indija produžila karantin do 3. maja
Indija je danas najavila produžetak restriktivnih mera i nacionalnog karantina zbog korona virusa do 3. maja.
"Indija je platila veliku ekonomsku cenu, ali je reagovala bolje od mnogih drugih zemalja brzim uvođenjem ograničenja putovanja i karantina, još pre nego što je registrovan prvi smrtni slučaj", izjavio je Modi i dodao da u zemlji nema nestašica hrane i lekova.
Najavio je i mogućnost da se od sledeće nedelje nadničarima i poljoprivrednim radnicima omogući da idu na njive i obrađuju zemlju.
Indija, sa 1,3 milijarde stanovnika, trenutno ima oko 9.000 zaraženih i oko 350 umrlih.
Brojke opadaju u Južnoj Koreji
Južna Koreja je prijavila 27 novih slučajeva zaraze korona virusom, što je 13. uzastopni dan u kom je broj novih infekcija ispod stotinu.
Prema podacima južnokorejskog Centra za kontrolu i prevenciju bolesti, ukupan broj zaraženih viši je od 10.000, umrlo je više od 220 osoba.
Južnokorejski premijer Čung Se Kjun pozvao je zvaničnike da pruže snažniju podršku naporima naučnika da razviju vakcinu za lečenje virusa, jer bi to bila blagodet za biomedicinsku industriju u zemlji.
Kina počela klinička testiranja, nema umrlih
Kina je odobrila dve eksperimentalne vakcine za Covid-19 i započela klinička testiranja.
U isto vreme, Kina je uvela kontrolu nad objavljivanjem akademskih istraživanja o poreklu korona virusa. Ta odluka centralne vlade je prvo objavljena na internet stranicama dva kineska univerziteta, a zatim je skinuta.
Kina je 14. aprila prijavila 89 novih slučajeva virusa, od kojih je 86 među putnicima koji su stigli iz inostranstva. Nije prijavljen nijedan smrtni slučaj. U Kini je od posledica korona virusa umrlo ukupno 3.341 a zaraženo je 82.249 ljudi.
U Japanu ogromne gužve u prodavnicama
U Japanu je prijavljeno 390 novih slučajeva zaraze korona virusom, čime je ukupan broj obolelih u toj zemlji povećan na 7.645.
Premijer Japana Šinzo Abe proglasio je prošle nedelje vanredno stanje u zemlji, a ljudima je preporučeno da rade od kuće.
Međutim, u prodavnicama i tržnim centrima u Tokiju su zabeležene ogromne gužve, jer ljudi kupuju velike količine hrane i druge potrepštine, stvarajući zalihe za mesec dana koliko će trajati vanredno stanje u Japanu.
U Singapuru najviše zaraženih u jednom danu
Singapur je prijavio najveći broj zaraženih korona virusom u jednom danu, njih 400. Time je broj zaraženih u ovoj azijskoj zemlji dostigao skoro 3.000.
Najveći broj zaraženih ima među stranim radnicima, kojih u Singapuru ima oko dvesta hiljada i koji žive u malim, gusto naseljenim kvartovima, zbog ćega predstavljaju epidemiološku pretnju.
Mere ostaju na snazi u Australiji i na Novom Zelandu
Australija i Novi Zeland neće ublažavati restriktivne mere, uprkos tome što se u obe zemlje beleži značajan pad broja zaraženih.
Australijski premijer Skot Morison je rekao da će se o ukidanju mera razmišljati za nekoliko sedmica.
"Strpljenje mora biti naša prednost", poručio je Skot i podsetio na primer Singapura u kom se javlja drugi talas zaraze korona virusom.
Australija, koja ima oko 25 miliona stanovnika, u poslednja dva dana registrovala je samo 63 nova slučaja, čime se ukupan broj popeo na oko 6.500. To je najmanji porast broja obolelih u poslednjih mesec dana.
Novi Zeland, koji ima oko pet miliona stanovnika, zebeležio je u utorak samo osam novozaraženih, pa ih je sada ukupno nešto više od 1.000. To je najmanji porast infekcija u prethodne tri nedelje.